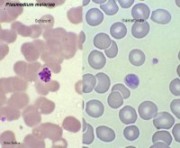

It is claimed by many historians that the colonization of the tropical parts of central Africa was prevented by the presence of terrible diseases, such as sleeping sickness, malaria and yellow fever, until well into the nineteenth century. Arab traders set up trading posts, such as the island of Zanzibar along the coast of East Africa, from the eighth century AD onwards, but they seldom ventured far inland for fear of contracting fatal illnesses. In the fifteenth century Dutch and Portuguese merchants arrived, but they too remained mainly in coastal settlements. The great civilizations of southern Africa, such as that of Zimbabwe, were never seen by outsiders until long after their decline. The local people possessed a certain amount of immunity to some of the diseases and this allowed them to survive and flourish.


A mosquito. (Right) The
needle-like proboscis (X250) penetrates the skin and can inject lethal
microbes into the victim's blood stream. © 1999 The Centre
for Microscopy and Microanalysis
It was only in the mid-nineteenth century that explorers, and eventually colonists, from Europe were able to settle in tropical Africa - when medical science was beginning to understand the importance of hygiene, the methods of transmission (vectors - see flies) and the causes of disease - microbes. But even then, explorers such as Stanley, Livingstone, Burton and Speke all contracted and suffered from fevers for most of their expeditions. Missionaries who established churches often fell victim to malaria, or another of the tropical diseases, and seldom lived for more than a few years. But then the latter half of the nineteenth century saw an unholy scramble by the European powers for territorial annexation, that resulted in the division of countries that we find today. Various ways were developed by the immigrants to cope with the diseases, varying from local remedies to inoculation, where and when such existed.

(Right) Trypanosoma brucei (Left) Plasmodium
falciparum
© University of Buffalo
Today sleeping sickness, which is spread by the tsetse fly, is still common in parts of Africa and malaria is still a threat in many parts of the world, despite strenuous efforts by the United Nations through the World Health Organization and others, to rid the tropics of these diseases.
In recent years there have been a number of public health problems arise in North America and Europe associated with tropical diseases that originate in the rainforest. Among these are:
- AIDS
- Ebola
- West Nile Virus
- Monkeypox
Of these AIDS is the only one that has so far proven to be a serious and
endemic (wide spread and permanent) threat. The others are serious
and potentially fatal illnesses, but they have not so far occured in anything
but isolated cases.
West Nile Virus, though, appeared in the New York area in the fall of 1999, and spread rapidly. Dozens of cases were treated, and a number of people died. The virus was controlled, but it was an illustration of how quickly a disease can appear, spread and become if not an epidemic, then a serious threat to public health.
Emerging Infectious Diseases Journal Homepage
The Diptera (Flies)
Globalization, Development and the Spread of Disease
- Medical Geography
- African Trypanosomiasis
- WHO Division of Control of Tropical Diseases - Dengue and DHF Control
- Dengue
- Mosquito
- Outbreak
- Vector-Borne
Disease Ecology and Epidemiology
2000 and beyond: Confronting the Microbe Menace
Mosquitos, Dead Birds and Epidemics
When did AIDS begin?
What new things are going to kill me?
Monkeypox - WHO Information Fact Sheet 161
World Forest Resources
Update: West Nile Virus Isolated from Mosquitoes --- New York, 2000
Teachers Wormhole

Go
to
Home
| Space Station
| Mars | Rainforest
© 1999 Satellite Events Enterprises Inc.